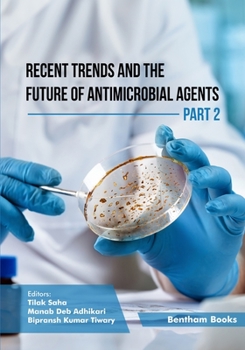
Paperback Recent Trends and The Future of Antimicrobial Agents - Part 2 Book

Recent Trends and The Future of Antimicrobial Agents - Part 2
Recent Trends and the Future of Antimicrobial Agents provides a significantly expanded overview of the topic with updated research in a broader context on the development of alternative approaches against microbial infections. This part primarily describes the use of probiotics, chemically synthesized compounds and nanomaterials as antimicrobial agents. The first chapter describes the potential of probiotics for the restoration of gut microbiomes. Amongst various antimicrobial agents, the use of antibodies has recently been investigated as a potential remedy. A chapter on antibody-based therapy as an alternative to antibiotics has been included. Chemical synthesis has eased the development of target-based prospective drug molecules against microorganisms. Chemically synthesized cationic amphiphiles and amphiphilic nanocarriers as antimicrobial agents have been discussed with sufficient detail in two different chapters. Research and progress in Schiff Base-Metal Complexes and Metal-Organic Frameworks for their antimicrobial applications have also been described in two separate chapters. Independent chapters discussing the design, synthesis and antimicrobial applications of biogenic metal or metalloid nanoparticles, bactericidal QDs and MoS2-based antibacterial nanocomposites have fulfilled the aim of incorporating cutting-edge research in the areas of alternative antimicrobials. Also, a new-age approach to combat microbes, antimicrobial photodynamic therapy (aPDT), is discussed in the final chapter of the edited volume. This part intends to provide the readers with an updated and broad view of research and development in alternative remedial approaches against microbial infections. The contents cater to the information needs of professionals and learners in academia, industry and health services who aim to learn the most significant experimental and practical approaches towards finding alternatives to existing antimicrobial therapies.
Format:Paperback
Language:English
ISBN:9815123998
ISBN13:9789815123999
Release Date:June 2023
Publisher:Bentham Science Publishers
Length:270 Pages
Weight:1.44 lbs.
Dimensions:0.7" x 7.0" x 10.0"
Customer Reviews
0 rating